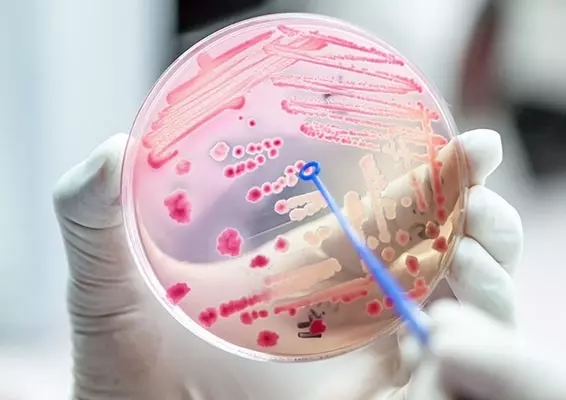

Sierpień 2022
W sierpniowym wydaniu czasopisma Forum Położnictwa i Ginekologii poruszamy temat sepsy i wstrząsu septycznego w ciąży. Sepsa położnicza jest jedną z głównych przyczyn śmiertelności okołoporodowej, której można zapobiec. Celem artykułu jest podsumowanie wiedzy na temat sepsy oraz dostarczenie informacji dotyczących postępowania w przypadku podejrzenia sepsy u kobiety w ciąży. Zaleca się, aby sepsę oraz wstrząs septyczny traktować jako stan nagły, który powinien być podejrzewany w przypadku infekcji oraz niewydolności narządów, której nie da się wyjaśnić w inny sposób, niezależnie od obecności gorączki u pacjentki. Leczenie obejmujące podanie szerokospektralnych antybiotyków, intensywnej resuscytacji płynowej oraz wazopresorów w razie wystąpienia objawów hipoperfuzji powinno rozpocząć się w jak najkrótszym czasie od postawienia diagnozy. Jakie są czynniki ryzyka? Jak diagnozować sepsę? Zapraszamy do lektury!
- Anna Zaradna , Agnieszka Drosdzol-Cop
- 12 września 2022
- Beata Wróbel
- 12 września 2022